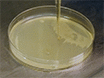

In Vivo Nanovector Delivery of a Heart-specific MicroRNA-sponge
- PMID: 29985373
- PMCID: PMC6101744
- DOI: 10.3791/57845 (VSports最新版本)
In Vivo Nanovector Delivery of a Heart-specific MicroRNA-sponge
Abstract
MicroRNA (miRNA) is small non-coding RNA which inhibits post-transcriptional messenger RNA (mRNA) expression. Human diseases, such as cancer and cardiovascular disease, have been shown to activate tissue and/or cell-specific miRNA expression associated with disease progression. The inhibition of miRNA expression offers the potential for a therapeutic intervention. However, traditional approaches to inhibit miRNAs, employing antagomir oligonucleotides, affect specific miRNA functions upon global delivery VSports手机版. Herein, we present a protocol for the in vivo cardio-specific inhibition of the miR-181 family in a rat model. A miRNA-sponge construct is designed to include 10 repeated anti-miR-181 binding sequences. The cardio-specific α-MHC promoter is cloned into the pEGFP backbone to drive the cardio-specific miR-181 miRNA-sponge expression. To create a stable cell line expressing the miR-181-sponge, myoblast H9c2 cells are transfected with the α-MHC-EGFP-miR-181-sponge construct and sorted by fluorescence-activated cell sorting (FACs) into GFP positive H9c2 cells which are cultured with neomycin (G418). Following stable growth in neomycin, monoclonal cell populations are established by additional FACs and single cell cloning. The resulting myoblast H9c2-miR-181-sponge-GFP cells exhibit a loss of function of miR-181 family members as assessed through the increased expression of miR-181 target proteins and compared to H9c2 cells expressing a scramble non-functional sponge. In addition, we develop a nanovector for the systemic delivery of the miR-181-sponge construct by complexing positively charged liposomal nanoparticles and negatively charged miR-181-sponge plasmids. In vivo imaging of GFP reveals that multiple tail vein injections of a nanovector over a three-week period are able to promote a significant expression of the miR-181-sponge in a cardio-specific manner. Importantly, a loss of miR-181 function is observed in the heart tissue but not in the kidney or the liver. The miRNA-sponge is a powerful method to inhibit tissue-specific miRNA expression. Driving the miRNA-sponge expression from a tissue-specific promoter provides specificity for the miRNA inhibition, which can be confined to a targeted organ or tissue. Furthermore, combining nanovector and miRNA-sponge technologies permits an effective delivery and tissue-specific miRNA inhibition in vivo. .
V体育官网 - References
-
- Hammond SM. microRNA detection comes of age. Nat Methods. 2006;3(1):12–13. - PubMed (V体育2025版)
-
- van Rooij E, Olson EN. MicroRNAs: powerful new regulators of heart disease and provocative therapeutic targets. The Journal of Clinical Investigation. 2007;117(9):2369–2376. - PMC (V体育官网) - PubMed
-
- Das S, et al. miR-181c regulates the mitochondrial genome, bioenergetics, and propensity for heart failure in vivo. PLoS One. 2014;9(5):e96820. - "V体育ios版" PMC - PubMed
Publication types
- Actions (VSports最新版本)
- "VSports" Actions
MeSH terms
- V体育平台登录 - Actions
Substances
Grants and funding
LinkOut - more resources
Full Text Sources
Other Literature Sources (VSports手机版)
V体育ios版 - Research Materials